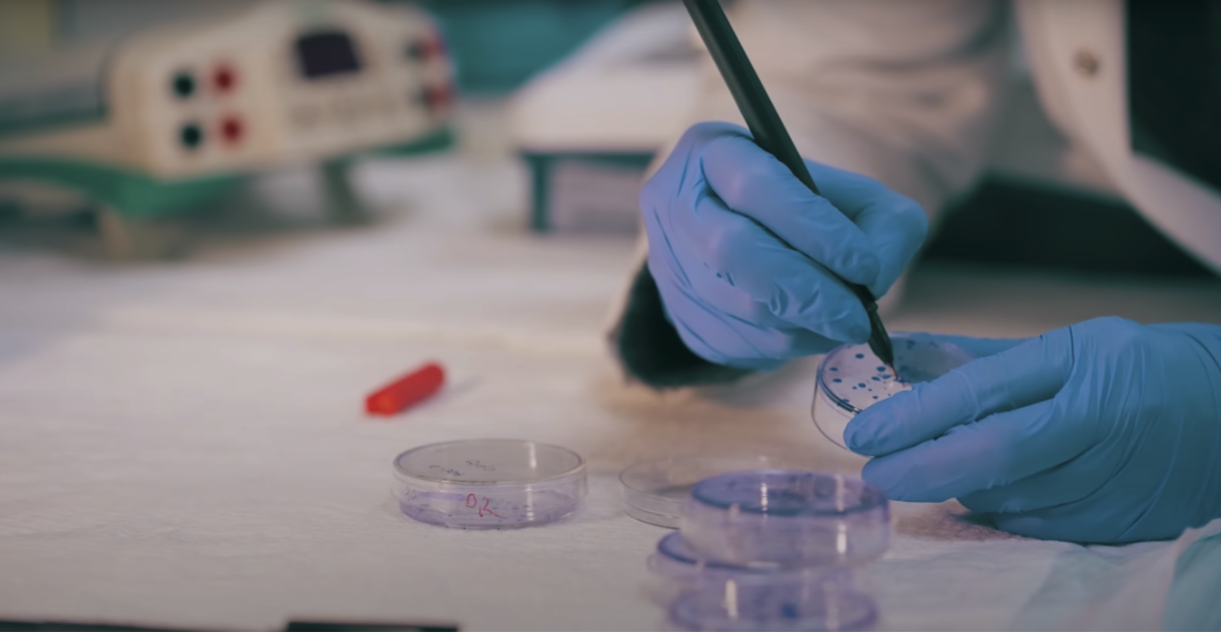

This detailed account unravels the chilling saga of the Zodiac Killer in San Francisco. Covering the brutal murders, cryptic letters sent to newspapers, and the killer's elusive identity, it highlights the terror inflicted on the city, the extensive investigations, and the enduring mystery. The film examines the impact on victims, police efforts, public fear, and the transformation of criminal forensics, painting a haunting picture of one of America's most notorious unsolved cases.